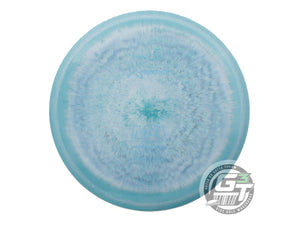
Prodigy AIR Spectrum M4 Midrange Golf Disc (Individually Listed)

Menu

Discraft Limited Edition 2026 Icon Team Ben Callaway Swirl Elite Z Undertaker Distance Driver Golf Disc (Individually Listed)
$18.99

Discraft Limited Edition 2026 PDGA World Championship Tour Series Special Blend Sled Putter Golf Disc (Individually Listed)
$24.99

Innova Limited Edition 2026 Tour Series Jen Allen Proto Glow Halo Champion Roc3 Midrange Golf Disc (Individually Listed)
$23.99

Discraft Limited Edition 2026 Icon Team Ben Callaway Swirl Elite Z Undertaker Distance Driver Golf Disc (Individually Listed)
$18.99

Discraft Limited Edition 2026 PDGA World Championship Tour Series Special Blend Sled Putter Golf Disc (Individually Listed)
$24.99

Innova Limited Edition 2026 Tour Series Jen Allen Proto Glow Halo Champion Roc3 Midrange Golf Disc (Individually Listed)
$23.99

Discraft Limited Edition 2026 Ledgestone Open Swirl Big Z Cigarra Fairway Driver Golf Disc (Individually Listed)
$19.99

Discraft Limited Edition 2026 Ledgestone Open Swirl Big Z Buzzz Midrange Golf Disc (Individually Listed)
$19.99

Discraft Limited Edition 2026 Ledgestone Open Sparkle Elite Z Avenger SS Distance Driver Golf Disc (Individually Listed)
$19.99

Axiom Limited Edition 2024 Team Series Halloween Edition Eagle McMahon Fission Pyro Midrange Golf Disc (Individually Listed)
$23.99

Axiom Limited Edition 2025 Team Series Halloween Edition Jeremy Koling Particle Eclipse Glow Proton Hex Midrange Golf Disc (Individually Listed)
$29.99
- HOME
- GIFT CARDS
-
STORE INFO.
Trending searches
Limited Edition

Discraft Limited Edition 2026 Icon Team Ben Callaway Swirl Elite Z Undertaker Distance Driver Golf Disc (Individually Listed)
- Price
- $18.99

Discraft Limited Edition 2026 PDGA World Championship Tour Series Special Blend Sled Putter Golf Disc (Individually Listed)
- Price
- $24.99

Innova Limited Edition 2026 Tour Series Jen Allen Proto Glow Halo Champion Roc3 Midrange Golf Disc (Individually Listed)
- Price
- $23.99
- SHOP DISCS
- SHOP PRODUCTS
-
NEW RELEASES

Discraft Limited Edition 2026 Icon Team Ben Callaway Swirl Elite Z Undertaker Distance Driver Golf Disc (Individually Listed)
$18.99
Discraft Limited Edition 2026 PDGA World Championship Tour Series Special Blend Sled Putter Golf Disc (Individually Listed)
$24.99
Innova Limited Edition 2026 Tour Series Jen Allen Proto Glow Halo Champion Roc3 Midrange Golf Disc (Individually Listed)
$23.99 -
LIMITED EDITION

Discraft Limited Edition 2026 Icon Team Ben Callaway Swirl Elite Z Undertaker Distance Driver Golf Disc (Individually Listed)
$18.99
Discraft Limited Edition 2026 PDGA World Championship Tour Series Special Blend Sled Putter Golf Disc (Individually Listed)
$24.99
Innova Limited Edition 2026 Tour Series Jen Allen Proto Glow Halo Champion Roc3 Midrange Golf Disc (Individually Listed)
$23.99
Discraft Limited Edition 2026 Ledgestone Open Swirl Big Z Cigarra Fairway Driver Golf Disc (Individually Listed)
$19.99
Discraft Limited Edition 2026 Ledgestone Open Swirl Big Z Buzzz Midrange Golf Disc (Individually Listed)
$19.99
Discraft Limited Edition 2026 Ledgestone Open Sparkle Elite Z Avenger SS Distance Driver Golf Disc (Individually Listed)
$19.99 -
SIGNATURE TOUR SERIES

Axiom Limited Edition 2024 Team Series Halloween Edition Eagle McMahon Fission Pyro Midrange Golf Disc (Individually Listed)
$23.99
Axiom Limited Edition 2025 Team Series Halloween Edition Jeremy Koling Particle Eclipse Glow Proton Hex Midrange Golf Disc (Individually Listed)
$29.99 -
SELECT STOREFRONT
SELECT STOREFRONT - WHOLESALE






![Axiom Neutron Crave [Sarah Hokom Signature] Fairway Driver Golf Disc (Individually Listed)](http://discgolfer.com/cdn/shop/files/6_3VPL4wvbEued4kdoKUf4Xi.jpg?v=1755718682)